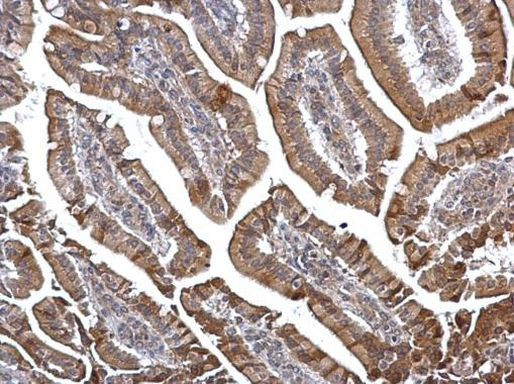
DOK6 Antibody in Immunohistochemistry (Paraffin) (IHC (P))

Search
Invitrogen
DOK6 Polyclonal Antibody
{{$productOrderCtrl.translations['antibody.pdp.commerceCard.promotion.promotions']}}
{{$productOrderCtrl.translations['antibody.pdp.commerceCard.promotion.viewpromo']}}
{{$productOrderCtrl.translations['antibody.pdp.commerceCard.promotion.promocode']}}: {{promo.promoCode}} {{promo.promoTitle}} {{promo.promoDescription}}. {{$productOrderCtrl.translations['antibody.pdp.commerceCard.promotion.learnmore']}}
产品信息
PA5-35875
宿主/亚型
分类
类型
抗原
偶联物
形式
浓度
规格
保存条件
运输条件
RRID
靶标信息
DOK-6 (docking protein 6), is a novel member of the Dok-4/5 subclass of the p62 Dok family of intracellular adaptor molecules. Dok-6 is highly expressed in the developing central nervous system and is co-expressed with Ret in several locations, including sympathetic, sensory, and parasympathetic ganglia, as well as in the ureteric buds of the developing kidneys. Pull-down assays using the Dok-6 phosphotyrosine binding (PTB) domain and GDNF-activated Ret indicate that Dok-6 binds to the phosphorylated Ret Tyr(1062) residue. Moreover, ligand activation of Ret resulted in phosphorylation of tyrosine residue(s) located within the unique C terminus of Dok-6 predominantly through a Src-dependent mechanism, indicating that Dok-6 is a substrate of the Ret-Src signaling pathway. (Crowder RJ, Enomoto H, Yang M, Johnson EM Jr, Milbrandt J. Dok-6, a Novel p62 Dok family member, promotes Ret-mediated neurite outgrowth. J Biol Chem. 2004 Oct 1;279(40):42072-81. Epub 2004 Jul 30. It is also known as DOK6, HsT3226, MGC20785 or IRS. 0.
⚠WARNING: This product can expose you to chemicals including mercury, which is known to the State of California to cause birth defects or other reproductive harm. For more information go to www.P65Warnings.ca.gov.
仅用于科研。不用于诊断过程。未经明确授权不得转售。